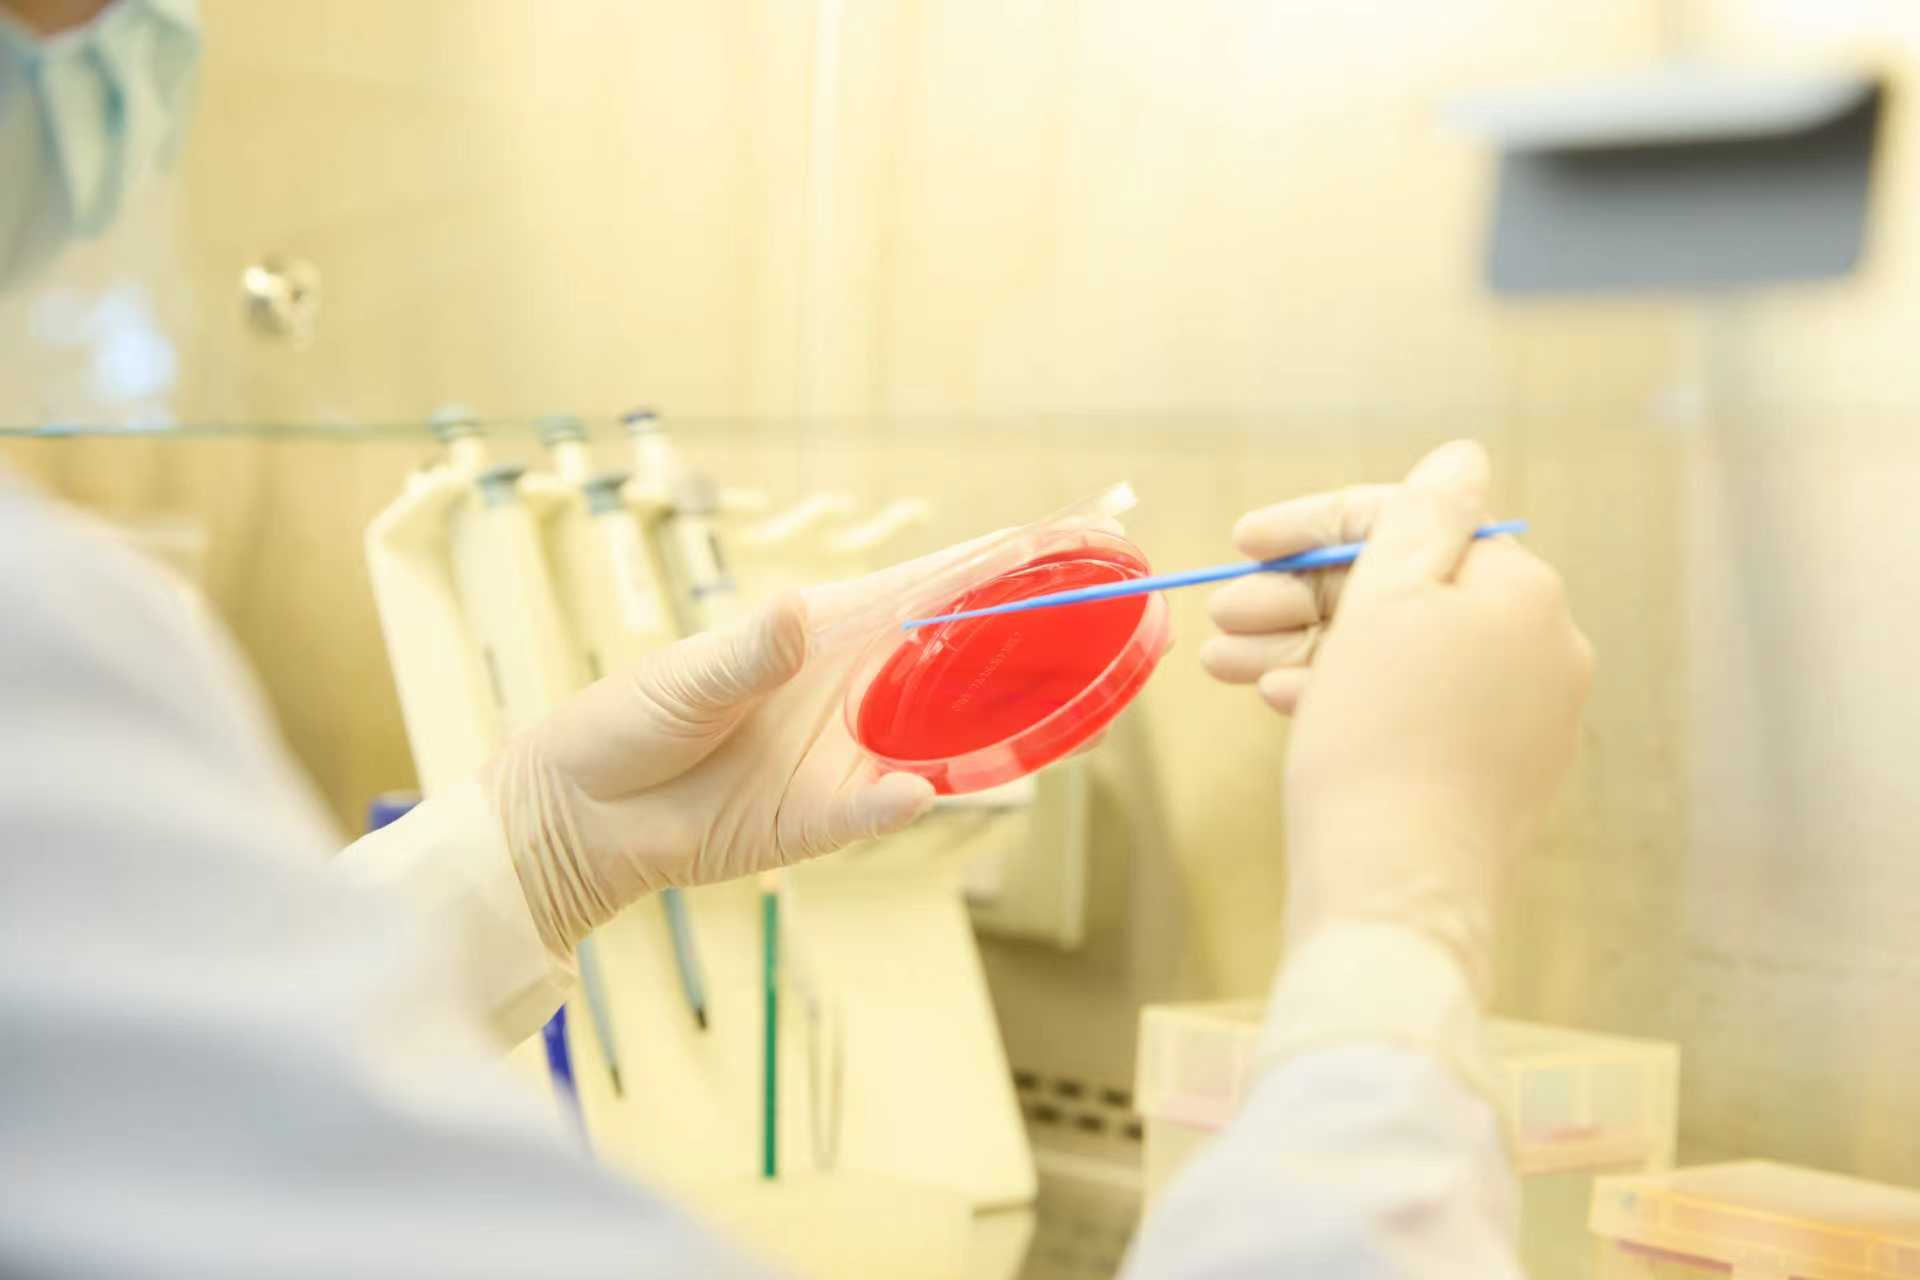

中国农业大学动物医院微生物组隶属于中国农业大学动物医院检验中心,微生物组拥有专业的技术团队与实验设备,为临床、科研、带教提供了强有力的技术支持。
微生物组配备有生物安全柜、药敏自动判读仪、电热恒温培养箱、生物显微镜、药敏分配器、超低温冰箱、高压灭菌器等设备,能够完成细菌培养、真菌培养、血液培养、细菌药敏试验、革兰氏染色、抗酸染色等多种专项检查,每年出具检验报告2000余单。
微生物组成员有着丰富的临床工作经验,能够提供准确的微生物检验结果与临床建议。实操组承担所有临床微生物检测标本涂片、接种、染色、镜检、菌种鉴定、药敏结果判读。药敏试验按照美国临床和实验室标准协会(Clinical and Laboratory Standards Institute,CLSI)推荐方法,采用纸片扩散法进行检测及结果判读。所有微生物报告结果均由审核组审核通过后出具,以确保报告的完整、准确、严谨。为进一步提高诊断准确性,所有细菌菌株均采用基质辅助激光解析电离飞行时间质谱(MALDI-TOF)进行鉴定,目前已形成实验室内部保菌库、玻片库、细菌耐药性数据库等。这些成果的积累,不仅为临床高质量微生物报告的出具保驾护航,更为临床科研试验提供优质的资源。
在开展临床检验工作的同时,微生物组同样注重团队建设及个人发展,在多部兽医专业期刊杂志,如中国畜牧兽医、中国兽医杂志、The Japanese Society of Veterinary Science等发表多篇文章,内容涉及小动物细菌、真菌、病毒以及寄生虫感染等方面。并参与《小动物内科学(第五版》、《猫内科学(第七版)》、《Laboratory Procedures for Veterinary Technicians,Seventh Edition》等10余本著作翻译。
微生物组在不断精进自我的同时,也承担着教学和社会公益任务,每年接收本科实习生100余名,研究生实习20余名,外院临床进修生30余名,让学员们了解微生物在临床医学中的实际应用。高度重视实习质量,安排具有丰富经验的检验技师进行专人带教,针对检验技术要点、实操难点、理论重点一一进行梳理和解答。实习期结束后,小组内带教也与进修人员保持深度合作和联系,方便及时沟通和交流。与此同时,微生物小组每年进行对外公益课程10余次,定期举办感染性疾病专题培训班,提高小动物诊疗行业对感染性疾病的重视和诊疗效果,以开放和热情的态度欢迎更多的兽医同仁与我们共同开拓感染性疾病诊断的未来。